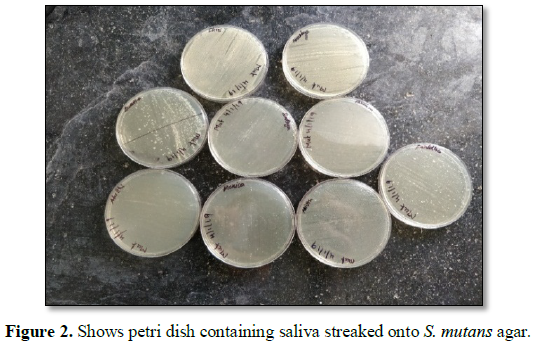

3106
Views & Citations2106
Likes & Shares
Background: Probiotics were defined as live microbes which when given in adequate amounts confer a health effect on the host. The effect of Lactobacillus having beneficial effect in caries prevention has been reported but not well recorded. The most common strains used for this are of the LAB (Lactic acid bacteria), Bifidobacterium strains and Lactobacillus. Probiotics have been tested by giving in different vehicles like milk, cheese, ice cream, capsules, supplements, yogurt, chewing gum, lozenges. The aim was to evaluate the effect of using probiotic yogurt that contains strains of L. casei on the Streptococcus mutans levels in the unstimulated saliva sample of patients undergoing fixed orthodontic treatment.
Materials and methods: A sample of 20 patients (11 females and 9 males) having fixed orthodontic appliance treatment were selected for this double blinded study where the dentist and investigator. 10 randomly selected subjects were asked to consume the probiotic yogurt twice daily in the morning and night for 15 days. 10 subjects were given yoghurt to consume that didn’t have any added probiotics. Probiotic yogurt was given to patients to consume one bottle of 200 ml morning and night. Saliva samples of the patients were collected in unstimulated manner in a sterilised container.
Results: After the use of the probiotic yoghurt, in some of the subjects there was reduction in the S. mutans levels; and in two subjects there was not much significant reduction. The subjects in the study group had lesser count of S. mutans than those in the control group.
Conclusion: This indicates that daily usage ingestion of a Lactobacilli casei Shirota derived probiotic through a yogurt form could reduce the levels of S. mutans in saliva around orthodontic brackets and bands and wires. These findings needs to be validated with future long term randomized clinical studies with a larger sample size.
Keywords: Lactobacillus, Probiotics, Streptococcus mutans, White spot lesions, Fixed orthodontic treatment
INTRODUCTION
The prevalence of white spot lesion lesions (WSLs) is reported to be up to 84% on the tooth surface [2]. Clinical studies with probiotic strains such as Lactobacillus rhamnosus GG, Lactobacillus reuteri, Bifidobacterium DN-173 010 or a Lactobacilli mix have consistently displayed a reduced prevalence of caries associated mutans streptococci in saliva .statistically significant (P<0.05) reduction of salivary mutans streptococci was registered after 2 weeks’ consumption of the test yogurt, while no alterations were found in the control group in this study. Fruit yogurt can be used as a vehicle for the probiotic supplement because of its high buffer capacity and non-erosive and low cariogenic potential. Moreover, yogurt is commonly preferred by adolescents and no compliance problems were experienced [3]. To have a beneficial effect in limiting or preventing dental caries, a probiotic must be able to adhere to dental surfaces and integrate into the bacterial communities making up the dental biofilm. It must also compete with and antagonize the cariogenic bacteria and thus prevent their proliferation. Finally, metabolism of food-grade sugars by the probiotic should result in low acid production. The advantage of incorporating probiotics into dairy products lies in their capacity to neutralize acidic conditions [4]. Lactobacillus strains are known to survive at pH 4.6, which is the common final acidity of many fermented dairy products; lower pH values (1 and 3) were examined. Although all of the examined strains were completely resistant to pH 3 even after 3 h of exposure, most of the strains displayed loss of viability when exposed to pH 1 for 1 h [5]. Streptococcus thermophiles and Lactobacillus lactis ssp. lactis were the only ones with the capacity to integrate into a biofilm present on a hydroxyapatite surface and to interfere with development of the cariogenic species Streptococcus sobrinus [5]. L. rhamnosus and the species L. casei has shown to inhibit in vitro growth of 2 important cariogenic streptococci [6]. Consumption of yogurt containing Lactobacillus reuteri over a period of 2 weeks reduced the concentration of S. mutans in the saliva by up to 80% [6].
In vitro studies have indicated the inhibitory properties of Lactobacillus shirota on periopathogenic and malodorous species such as Porphyromonas gingivalis and Fusobacterium nucleatum. Four weeks of consumption of 6.5 × 109 viable LcS per day by healthy denture wearers revealed a transient colonization of the oral cavity and denture surfaces by this strain during the consumption period and for up to 7 weeks of washout, as well as no significant effect on acidogenic populations such as levels of Lactobacilli and Streptococci [7]. The aim of this study is to examine for the possible effect of Lactobacilli casein Shirota given in the form of probiotic yoghurt given for short term consumption in reducing the levels of S. mutans in saliva in orthodontic fixed appliance patients.
MATERIALS AND METHODS
The study was proposed to be a randomized study where the investigator and the patients was blinded, consisting of twenty patients having fixed orthodontic treatment and were selected by lottery method of randomization. This study was conducted in the Department of Orthodontics and Dentofacial Orthopedics in Saveetha Dental College Chennai. The ethical clearance for this study was approved by Institutional human ethical review board of Saveetha Dental College.
Inclusion criteria
· Orthodontic treatment: Fixed appliance
· Demographic distribution: Indian patients, age group 13-30 years of age, the gender of the patient wasn’t taken into consideration
· All permanent teeth erupted except 3rd molars
· Currently not under any medications
· No mouthwash should be used while participating in the study as we wanted to avoid the action chemicals in the mouthwash interfering with the probiotic organisms
· Patient with good periodontal condition
· No active carious lesion
· Daily tooth brushing habit
Exclusion criteria
· Periodontal problems
· Patient with known medical conditions
20 patients were given yoghurt to consume in the morning and night for 15 days.
Methodology
Patients were instructed to drink the yogurt after keeping in the mouth for few minutes Patients were asked to brush twice daily for 3 min; this was shown by the operator. They were instructed to not intake any food or beverage 30 min before and after having the probiotic and avoid chewing gums, mouthwashes, and medications during the study. The yogurts were to be administered to the patients from day 1 after the first unstimulated saliva sample and continued until day 15. Saliva samples were to be again taken and evaluated at the end of 15 days. At next appointment, unstimulated saliva samples of the patient were collected in a sterile container and immediately transferred to the laboratory.
The saliva was then streaked onto S. mutans agar and inoculated for 1 day at 37°C in S. mutans agar as shown in Figure 2 and the colony count of S. mutans was counted. After incubation the count of S. mutans colonies were counted in a digital colony counter. The counts were recorded in the colony forming units/ml (cfu/ml). Preliminary confirmation of the colonies was done by gram staining and biochemical characterization assays.
RESULTS
The data was processed using Statistical Package for Social Sciences (SPSS). Pre and post treatment values were compared. The following tables are those showing the paired T-test and descriptive statistics of the collected data. Significance level was established at P<0.05.
Table 1 show that there is positive correlation between consumption of yoghurt and reduce in S. mutans count. Table 2 shows that the mean CFU of S. mutans reduces by about 20 CFU. There is decrease in the S. mutans count after consumption of yogurt containing probiotic Lactobacillus and this is evident from the data we have collected. Table 3 represents Kurtosis descriptive statistics of the data.
DISCUSSION
In this study, the consumption of yogurt containing probiotic bacteria and the levels of S. mutans in the unstimulated saliva of fixed orthodontic patients was reduced to a significant level. This study was focused on patients with fixed orthodontic appliance as they have an increased risk to develop caries and white spot lesions. Brackets play a vital role in this, as they are bonded to the teeth, making it difficult for the patient to cleanse and enamel surface is etched for this bracket to be bonded. Bacteria adhere to the pathogenic plaque that adheres to the orthodontic bracket and then there is change in the oral environment and saliva in patients who are in fixed orthodontic appliances. Metallic brackets have high critical surface tension and hence and increased risk of enamel demineralization [7]. At least some of the probiotic bacteria used in various probiotic products may colonize the oral cavity during the time they are in use; thus, the effects of probiotic bacteria in the oral cavity are important to understand. Probiotic bacteria seem to affect both oral microbiota and immune responses. L.GG (Lactobacillus rhamnosus GG, a well-studied strain, has been shown to be able to colonise the oral cavity for at least two weeks after discontinuation of consumption of the yoghurt. Despite great efforts, our understanding of the underlying mechanisms of probiotic behavior is still inadequate, however. As mixed-species biofilms are undoubtedly the dominant form in nature and the oral cavity, there are pressing needs to discover behaviors of bacteria and yeasts in a more complex system [8]. As mixed-species biofilms are undoubtedly the dominant form in nature and the oral cavity, there are pressing needs to discover behaviors of bacteria and yeasts in a more complex system [9]. Probiotic can be provided in the form of fruit juices, prebiotic fibres, milk based food like yogurt, cheese, kefir, bio drink and in the form of supplements like powder, capsule, gelatin tablets [1]. Consumption of fruit yogurt containing Bifidobaterium animalis subsp. lactis has been studied to reduce the levels of S mutans in orthodontic patients with fixed appliance [4]. The positive effects of the lozenges containing same probiotic strain (L. brevis CD2) on gingivitis, periodontitis, and other oral lesions as well. One recent study found effective reduction in Streptococcus mutans concentration in orthodontic patients in response to probiotic curd and toothpaste [10]. Short‑term ingestion of a Lactobacilli brevis derived probiotic through a lozenge tablet could reduce the levels of S. mutans in plaque around orthodontic brackets. Probiotic lozenges have shown to have a potential therapeutic value for the prevention of demineralization and white spot lesions formation during orthodontic treatment [1]. Probiotic strains administered for oral care are microorganisms mainly used to obtain gastrointestinal benefits, so they might not be ideal for the oral environment, quite different from the intestinal habitat. The effect of probiotics on dental caries and its related risk factors has been evaluated in several experimental studies using different strains; Lactobacillus rhamnosus GG, L. casei, L. reuteri, L. plantarum, L. brevis CD2, Bifidobacterium spp. etc. were proposed and used to obtain caries incidence reduction, mutans streptococci and lactobacilli count change, plaque pH control and root caries lesions reversal [11-15].
Caries promoting bacteria are S. mutans, these bacteria are both acidogenic and aciduric. Association of mutans streptococci with the initiation and prevalence of caries has been clearly established in several epidemiological studies [12-18]. The level of Streptococcus mutans in saliva has been shown to correlate with both past caries experience and future caries activity [17].
CONCLUSION
According to our data; the oral use of probiotic yogurt (L. brevis CD2) had significant effect on the S. mutans levels in the saliva of orthodontic patients. There was a significant decrease in the S. mutans count after consuming probiotic yogurt. Therefore it can be said that probiotics can be used to prevent white spot lesions and dental caries. Further studies with close follow up and long-time consumption of the probiotic can be done in a larger sample size for conclusive results and to determine its exact mechanism.
CONFLICTS OF INTEREST
There are no conflicts of interest.
ACKNOWLEDGEMENT
Many thanks to my guides for helping me with the study. Department of microbiology is thanked for helping me with the mounting the sample and for colony count with microscope.
FUNDING
This study was funded by self-funded.
1. Chaturvedi S, Jain U, Prakash A, Sharma A, Shukla C, et al. (2016) Efficacy of probiotic lozenges to reduce Streptococcus mutans in plaque around orthodontic brackets. J Indian Orthod Soc. Available from: https://link.galegroup.com/apps/doc/A581017776/AONE?sid=lms
2. Mizrahi E (1982) Enamel demineralization following orthodontic treatment. Am J Orthod 82: 62-67.
3. Cildir SK, Germec D, Sandalli N, Ozdemir FI, Arun T, et al. (2009) Reduction of salivary mutans streptococci in orthodontic patients during daily consumption of yoghurt containing probiotic bacteria. Eur J Orthod 31: 407-411.
4. Maragkoudakis PA, Zoumpopoulou G, Miaris C, Kalantzopoulos G, Pot B, et al. (2006) Probiotic potential of Lactobacillus strains isolated from dairy products. Int Dairy J 16: 189-199.
5. Comelli EM, Guggenheim B, Stingele F, Neeser JR (2002) Selection of dairy bacterial strains as probiotics for oral health. Eur J Oral Sci 110: 218-224.
6. Nikawa H, Makihira S, Fukushima H, Nishimura H, Ozaki Y, et al. (2004) Lactobacillus reuteri in bovine milk fermented decreases the oral carriage of mutans streptococci. Int J Food Microbiol 95: 219-223.
7. Eliades T, Eliades G, Brantley WA (1995) Microbial attachment on orthodontic appliances: I. Wettability and early pellicle formation on bracket materials. Am J Orthod Dentofacial Orthop 108: 351-360.
8. Jiang Q, Stamatova I, Kainulainen V, Korpela R, Meurman JH (2016) Interactions between Lactobacillus rhamnosus GG and oral microorganisms in an in vitro biofilm model. BMC Microbiol 16: 149.
9. Jiang Q, Stamatova I, Kainulainen V, Korpela R, Meurman JH (2016) Interactions between Lactobacillus rhamnosus GG and oral micro-organisms in an in vitro biofilm model. BMC Microbiol. 16: 149.
10. Jose JE, Padmanabhan S, Chitharanjan AB (2013) Systemic consumption of probiotic curd and use of probiotic toothpaste to reduce Streptococcus mutans in plaque around orthodontic brackets. Am J Orthod Dentofacial Orthop 144: 67-72.
11. Twetman S, Keller MK (2012) Probiotics for caries prevention and control. Adv Dent Res 24: 98-102.
12. Taipale T, Pienihakkinen K, Isolauri E, Larsen C, Brockmann E (2011) Bifidobacterium animalis subsp. lactis BB-12 in reducing the risk of infections in infancy. Br J Nutr 105: 409-416.
13. Campus G, Cocco F, Carta G, Cagetti MG, Simmer-Mattson C, et al. (2014) Effect of a daily dose of Lactobacillus brevis CD2 lozenges in high caries risk school children. Clin Oral Investig 18: 555-561.
14. Marttinen A, Haukioja A, Karjalainen S, Nylund L, Satokari R, et al. (2012) Short-term consumption of probiotic lactobacilli has no effect on acid production of supragingival plaque. Clin Oral Investig 16: 797-803.
15. Zickert I, Emilson CG, Krasse B (1982) Streptococcus mutans, lactobacilli and dental health in 13-14 year old Swedish children. Community Dent Oral Epidemiol 10: 77-81.
16. Bratthall D, Serinirach R, Carlsson P, Lekfuangfu S (1986) Streptococcus mutans and dental caries in urban and rural school children in Thailand. Community Dent Oral Epidemiol 14: 274-276.
17. Köhler B, Bjarnason S (1987) Mutans streptococci, lactobacilli and caries prevalence in 11 and 12 year old Icelandic children. Community Dent Oral Epidemiol 15: 332-335.
18. Klock B, Krasse B (1977) Microbial and salivary conditions in 9 to 12 year old children. Eur J Oral Sci 85: 56-63.
QUICK LINKS
- SUBMIT MANUSCRIPT
- RECOMMEND THE JOURNAL
-
SUBSCRIBE FOR ALERTS
RELATED JOURNALS
- BioMed Research Journal (ISSN:2578-8892)
- Journal of Ageing and Restorative Medicine (ISSN:2637-7403)
- Archive of Obstetrics Gynecology and Reproductive Medicine (ISSN:2640-2297)
- Journal of Psychiatry and Psychology Research (ISSN:2640-6136)
- Advance Research on Endocrinology and Metabolism (ISSN: 2689-8209)
- International Journal of Radiography Imaging & Radiation Therapy (ISSN:2642-0392)
- Journal of Neurosurgery Imaging and Techniques (ISSN:2473-1943)